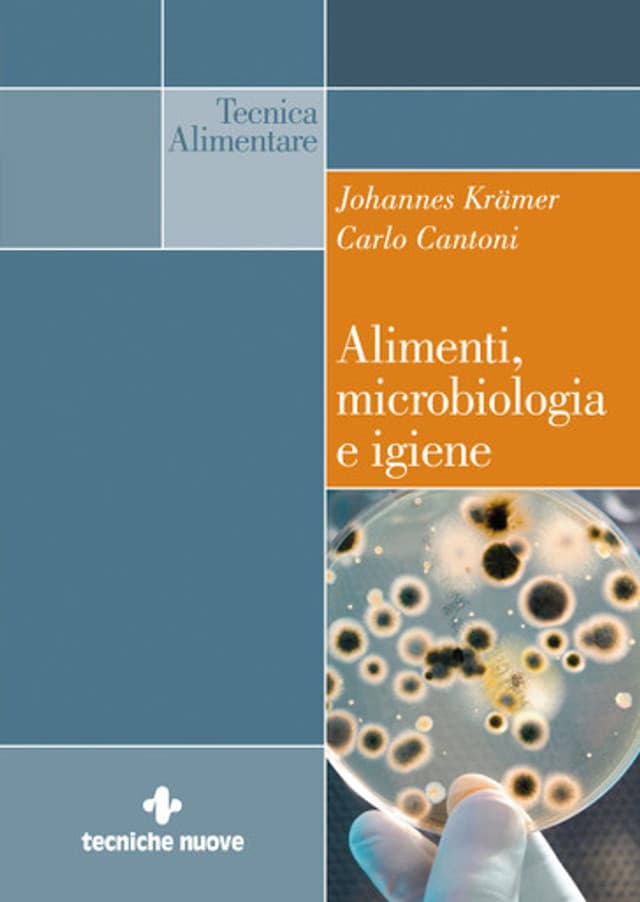

Alimenti, microbiologia e igiene
Formato:
Prodotto non disponibile
Spedizione gratuita per ordine sopra i 19 euro

Questo articolo è acquistabile con Carta della cultura giovani e Carta del merito, Carta del docente.
Dettagli
Edizione1
Data pubblicazione02/2011
Pagine496
RilegaturaBrossura
Isbn978-88-481-2471-3
Informazioni libro
Altri prodotti in Tecnologie Industriali
La modellistica dell’abbigliamento. Corpini, abiti, capispalla Vol. 2 Parte II
Le autrici de La modellistica dell’abbigliamento Vol.
di Annunziata Ruggeri, Rosaria Carvelli
23,66 €
Pneumatica – Corso completo
Il settore dell'automazione, ed in particolare dell'automazione a fluido di tipo pneumatico, sta acquistando sempre maggior importanza.
di Andrea Manuello Bertetto, Guido Belforte, Luigi Mazza
Promo
-5%19,86 €20,90 €
Scienza del latte
Si tratta di un’opera importante e aggiornata, una vera enciclopedia del latte, frutto di una intera vita spesa a conoscere, a sempre meglio conoscere le infinite verità che il latte contiene e che l’uomo adagio adagio scopre; un’opera che difficilmente troverà concorrenti in un’epoca tesa alla massima specializzazione e che tende perciò a separare del tutto la biochimica dalla fisico-chimica, la microbiologia dalla tecnologia, la strutturistica dalla ricerca dei nuovi prodotti.
di Charles Alais
Promo
-5%58,81 €61,90 €
Azionamenti elettrici di avanzamento nell’automazione industriale
Il volume fornisce un’ampia panoramica dei principi fisici e tecnologici della tecnica di regolazione e di azionamento.
di Georg Wiegartner, Hans Gross, Jens Hamann
Promo
-5%43,70 €46,00 €
Manuale degli utensili
Il “Manuale degli Utensili” appare in un momento particolarmente delicato e importante per lo sviluppo e il potenziamento di tecnologie innovative in Italia, poiché si sta consolidando finalmente una presa di coscienza dell’impatto strategico della ricerca tecnologica sull’economia.
di Franco Rabezzana
Promo
-5%95,00 €100,00 €
Manuale dello stampista
Il rapido esaurirsi della prima edizione ha determinato la necessità di pubblicarne una seconda nella quale è stata corretta qualche imprecisione – del resto inevitabile data la vastità e la ponderosità della materia – ma soprattutto la materia stessa e la sua trattazione sono state rese più aderenti al tipo di tecnici ai quali il libro è destinato.
di AA. VV.
Promo
-5%76,00 €80,00 €
Le altre cosmesi
Esistono le altre cosmesi? Secondo gli autori, sì.
di Elena Passerini, Gianni Proserpio
Promo
-5%19,00 €20,00 €
Manuale di Trattamenti e Finiture
Il settore dell'industria delle superfici è andato assumendo un'importanza crescente negli ultimi anni, caratterizzandosi per la presenza di costanti innovazioni.
di AA. VV.
Promo
-5%151,05 €159,00 €
Manuale degli organi delle macchine
Da decenni quest’opera (che proviene dalla prestigiosa Technische Universität di Monaco di Baviera) è uno dei riferimenti indiscussi, non solo in Germania ma anche in Italia e in molti altri paesi europei, nel campo dello studio, del progetto, del calcolo e della verifica degli elementi delle macchine.
di Berndt-Robert Höhn, Gustav Niemann, Hans Winter
Promo
-5%132,05 €139,00 €
Manuale di manutenzione industriale
Questo manuale colma una lacuna nel panorama dell’editoria tecnica italiana: un’opera che raccolga in maniera organica le più recenti conquiste della manutenzione sviluppandole in sintonia col progredire delle funzioni a cui si affianca e dalle quali talvolta viene integrata.
di AA. VV.
Promo
-5%94,05 €99,00 €